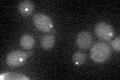
YMR055C
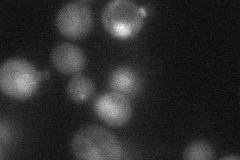
YMR055C
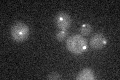
YMR055C

View description
Mitotic exit network regulator, forms GTPase-activating Bfa1p-Bub2p complex that binds Tem1p and spindle pole bodies, blocks cell cycle progression before anaphase in response to spindle and kinetochore damage
Localization:
Intensity:
Fold change:
Significance:
-
C’ GFP library in SD
punctate19.57 -
N' NOP1pr-GFP in SD

punctate22.2647 -
N' TEF2pr-mCherry in SD
cytosol,nucleus25.3685 -
N' NATIVEpr-GFP in SD

punctate16.0866 -
N' TEF2pr-VC and Cyto-VN in SD

#N/A0 -
C’ GFP library in SD+DTT

punctate201.02No -
C’ GFP library in SD+H2O2

punctate18.440.94No -
C’ GFP library in Starvation Media
punctate17.070.87No -
C’ GFP library on the background of Pup2-DaMP

punctate -
C’ GFP library on the background of CCT mutant

punctate25.00621.27708No
